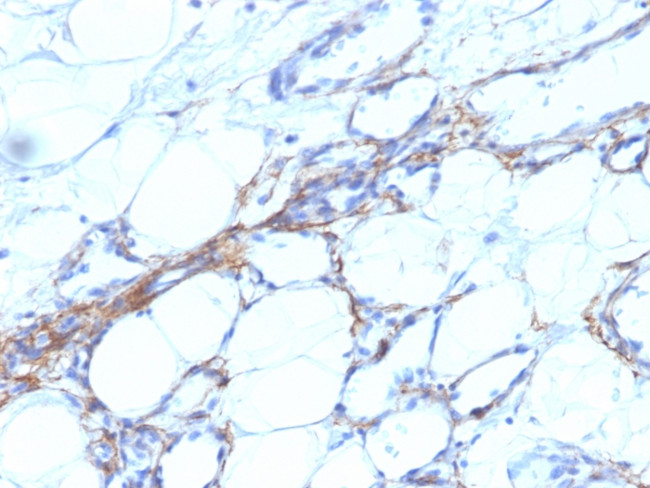
Smooth Muscle Myosin Heavy Chain (SM-MHC) Antibody in Immunohistochemistry (Paraffin) (IHC (P))

Search
NeoBiotechnologies
Smooth Muscle Myosin Heavy Chain (SM-MHC) Monoclonal Antibody (SPM201)
{{$productOrderCtrl.translations['antibody.pdp.commerceCard.promotion.promotions']}}
{{$productOrderCtrl.translations['antibody.pdp.commerceCard.promotion.viewpromo']}}
{{$productOrderCtrl.translations['antibody.pdp.commerceCard.promotion.promocode']}}: {{promo.promoCode}} {{promo.promoTitle}} {{promo.promoDescription}}. {{$productOrderCtrl.translations['antibody.pdp.commerceCard.promotion.learnmore']}}
产品信息
4629-MSM1X-P0
种属反应
宿主/亚型
分类
类型
克隆号
抗原
偶联物
形式
浓度
纯化类型
保存液
内含物
保存条件
运输条件
靶标信息
SM-MHC is a cytoplasmic structural protein, which is a major component of the contractile apparatus in smooth muscle cells. Expression of smooth muscle myosin is developmently regulated, appearing early in smooth muscle development, and is specific for smooth muscle development. Two isoforms of smooth muscle myosin heavy chain have been identified, designated MHC-1 and MHC-2.
仅用于科研。不用于诊断过程。未经明确授权不得转售。
篇参考文献 (0)
生物信息学
蛋白别名: contractile protein; gizzard smooth muscle; MHC; myh11 {ECO:0000312|RGD:3136}; myosin heavy chain; Myosin heavy chain 11; myosin heavy chain 21; myosin heavy chain SMA; myosin heavy chain, gizzard smooth muscle; Myosin heavy chain, smooth muscle isoform; myosin, heavy chain 11, smooth muscle; myosin, heavy polypeptide 11, smooth muscle; Myosin-11; SMMHC; smooth muscle myosin heavy chain; unnamed protein product
基因别名: AAT4; FAA4; KIAA0866; MYH11; PBV1SPCR2; SMHC; SMMHC
UniProt ID: (Human) P35749, (Rabbit) P35748